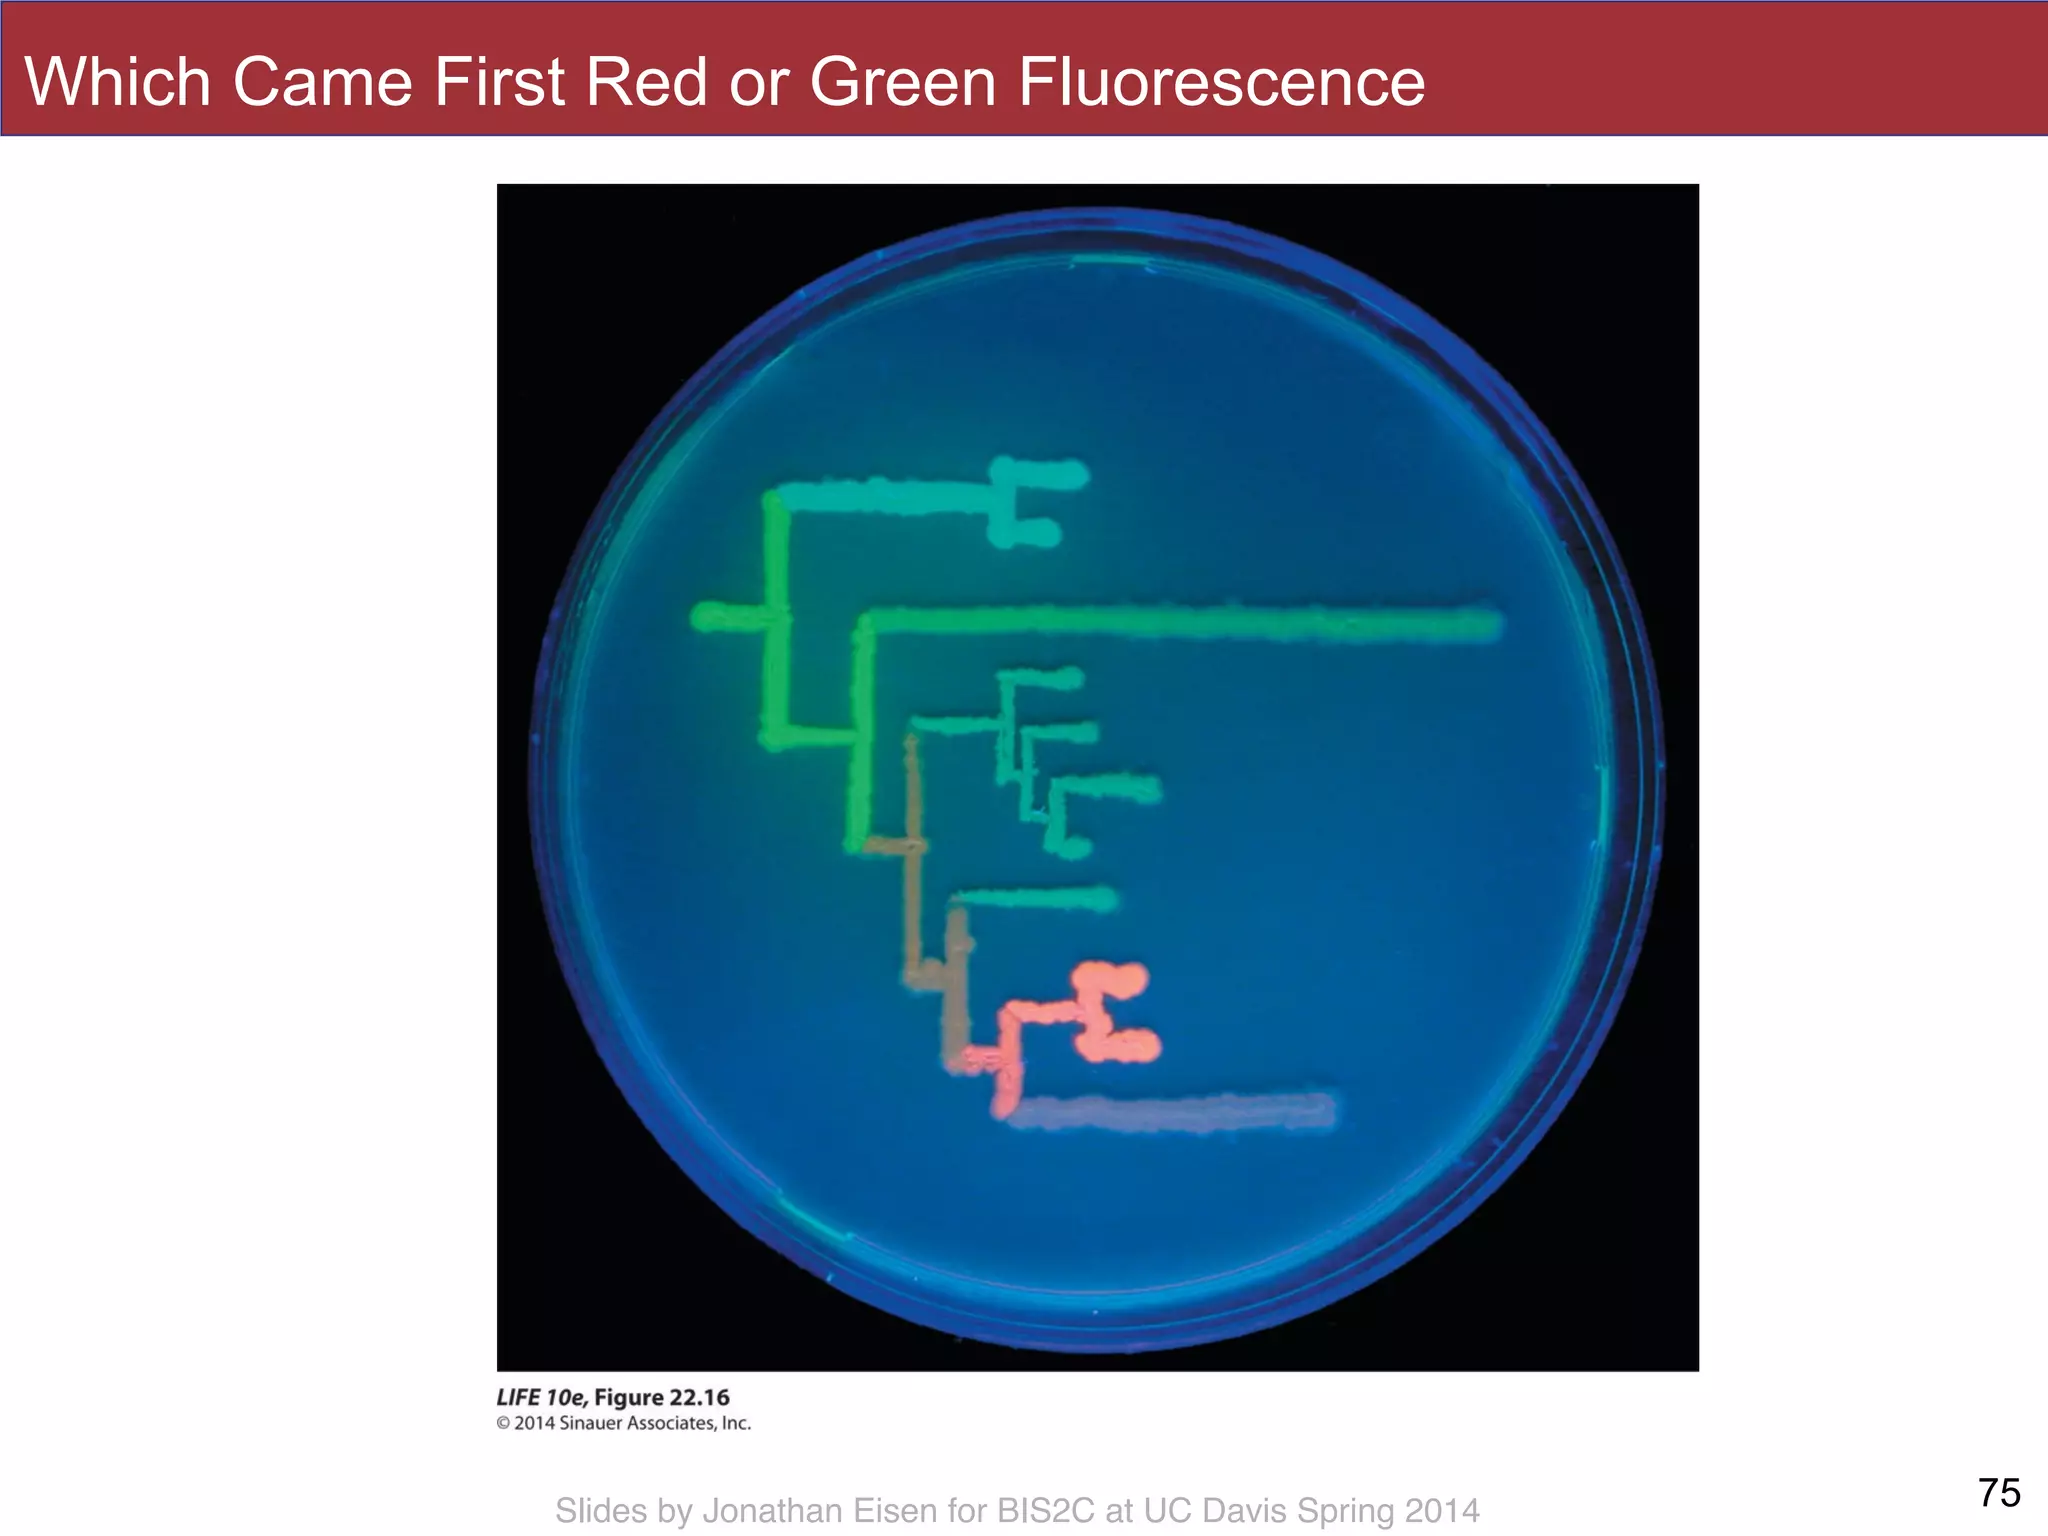
Slides by Jonathan Eisen for BIS2C at UC Davis Spring 2014
Which Came First Red or Green Fluorescence
75
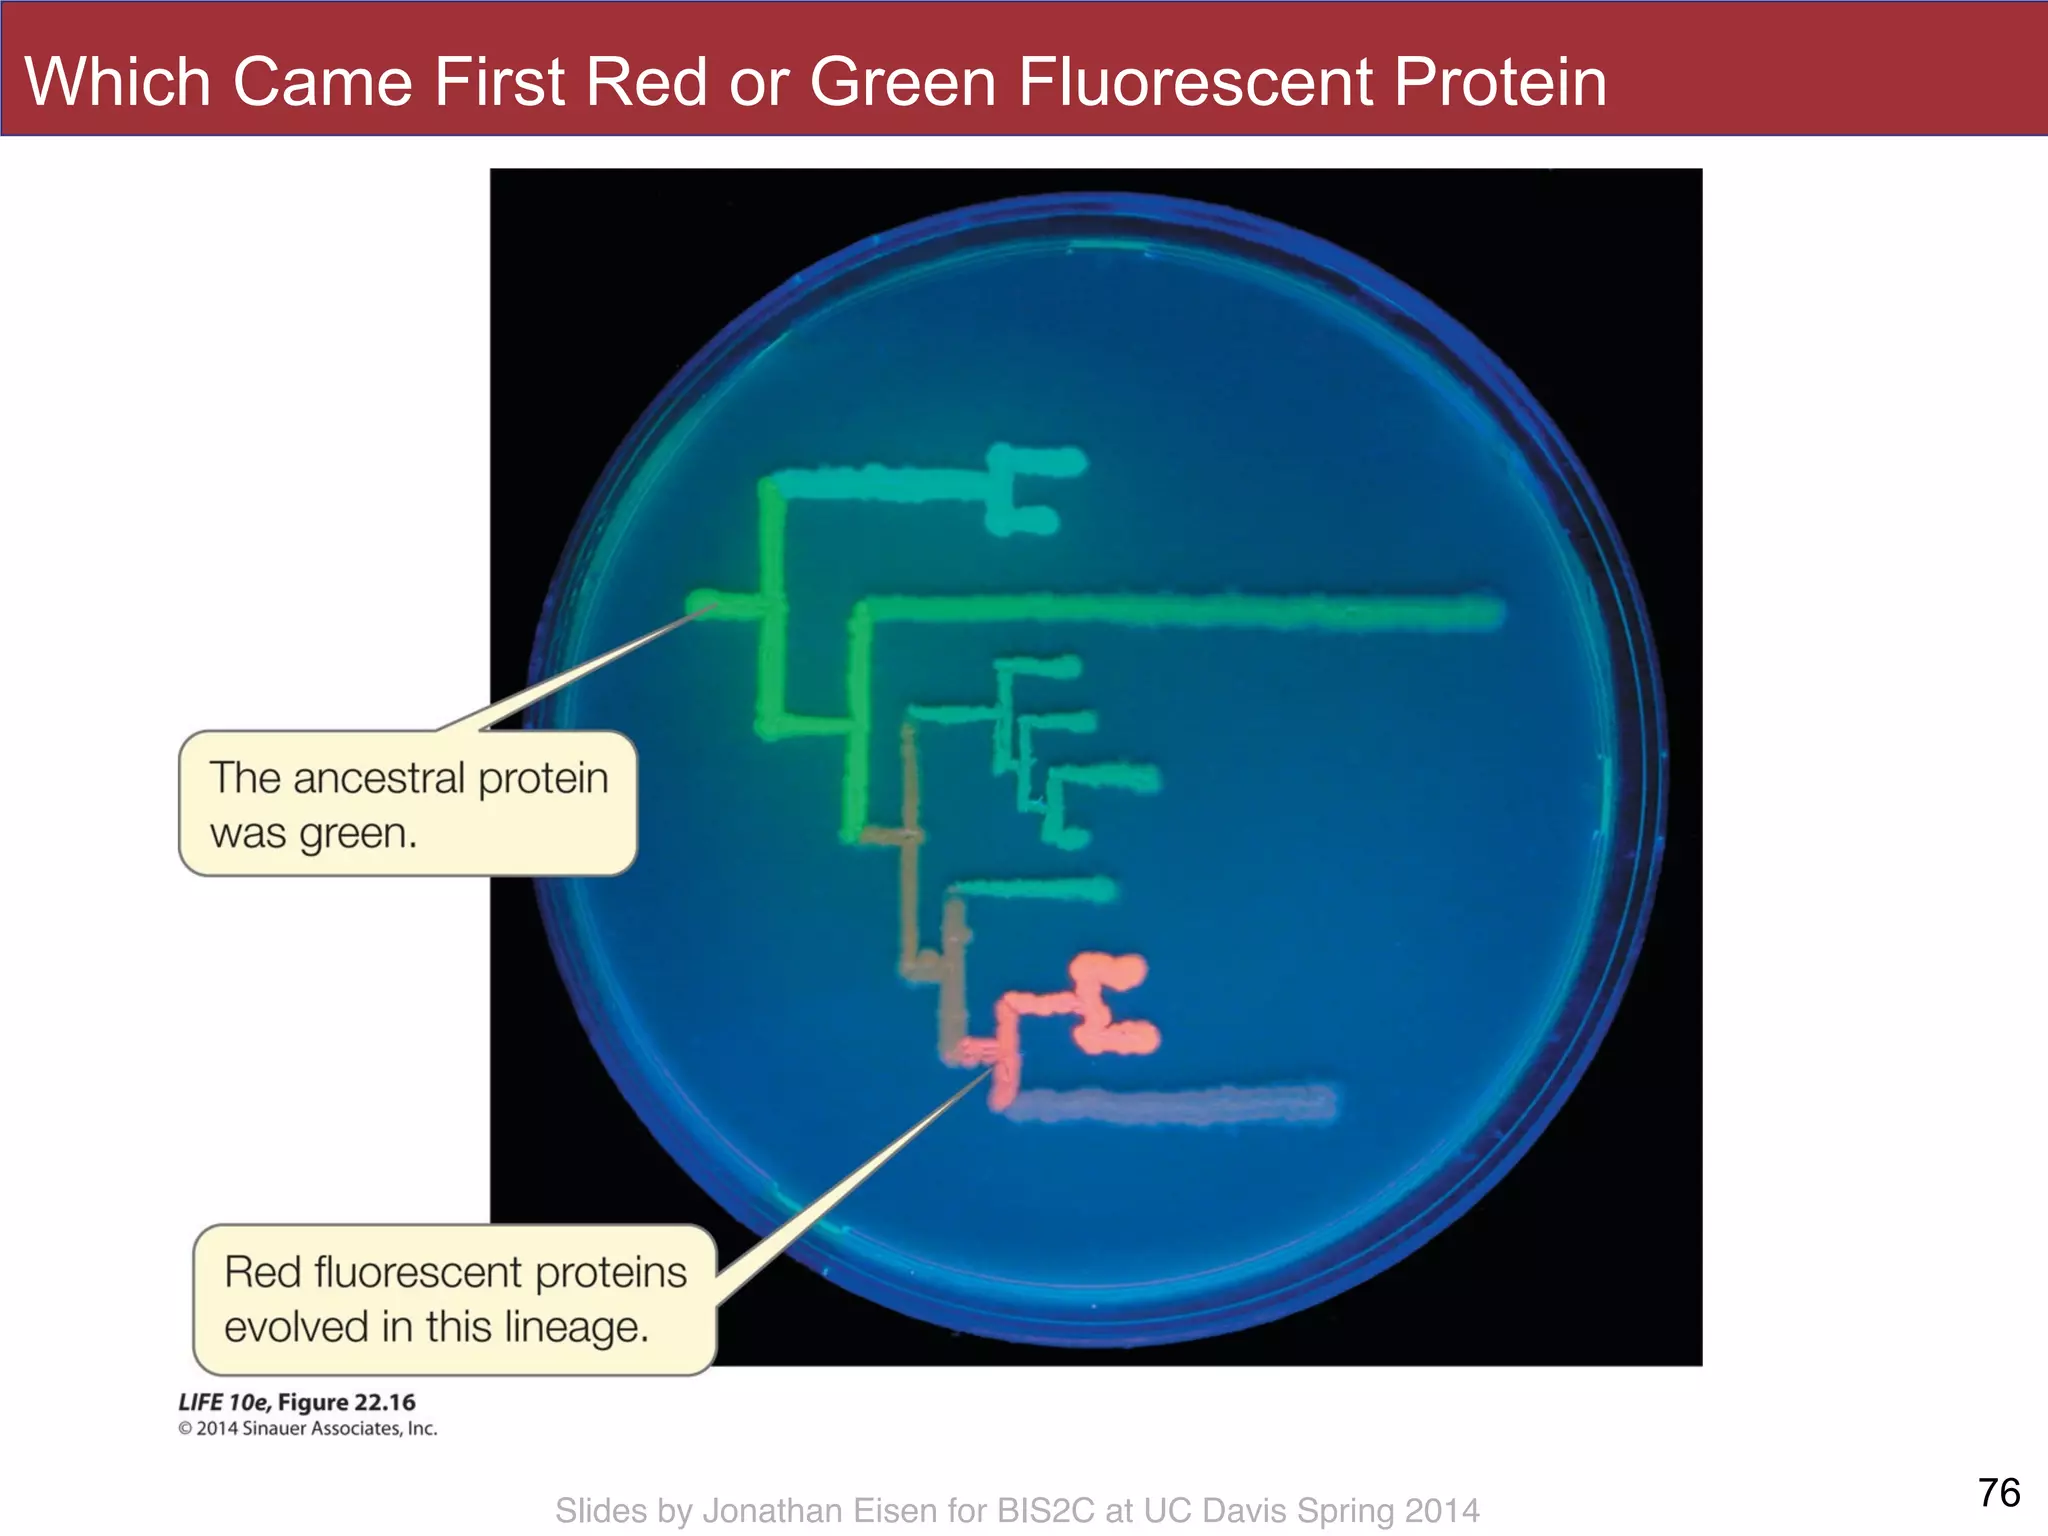
Slides by Jonathan Eisen for BIS2C at UC Davis Spring 2014
Which Came First Red or Green Fluorescent Protein
76

The document outlines the course structure for BIS 002C at UC Davis, focusing on biodiversity and phylogenetic trees. It includes administrative details, scheduling, grading policies, resources, and key concepts related to the course, such as understanding evolutionary history through phylogenetic trees. The lecture series aims to expand knowledge on biodiversity and the relationships among different organisms.